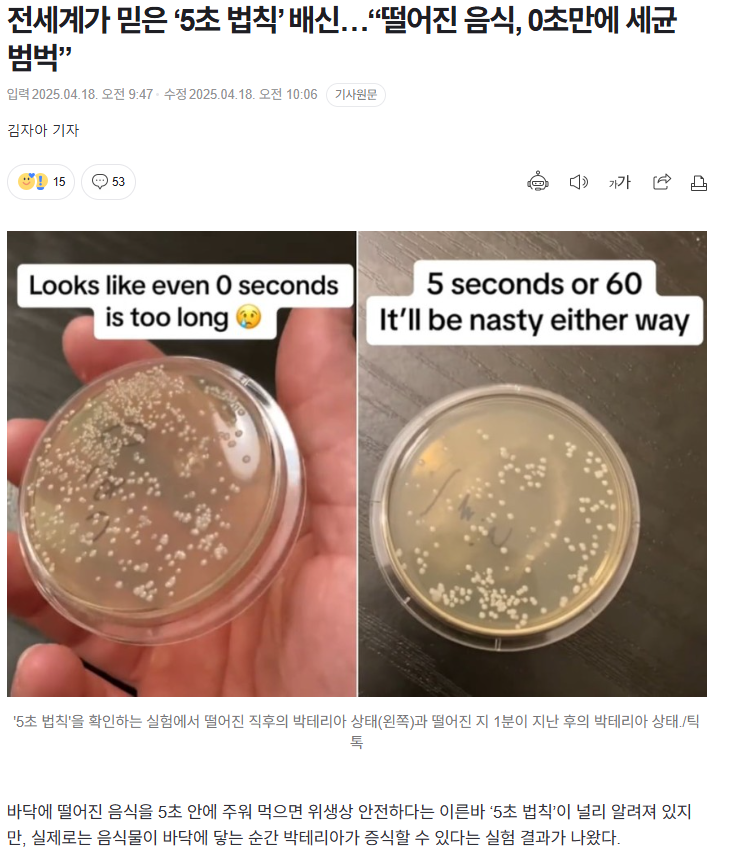
NLaPrL

|
이벤트 공지
|
|
💚베지밀X더쿠🧡 베지밀 신제품 바나나땅콩버터쉐이크 꼬르륵잠금🔒 체험단 모집!
67 |
00:05 |
798 |
|
공지
|
|
[공지] 언금 공지 해제
|
24.12.06 |
5,022,545 |
|
공지
|
|
📢📢【매우중요】 비밀번호 변경 권장 (현재 팝업 알림중)
|
24.04.09 |
12,081,345 |
|
공지
|
|
공지가 길다면 한번씩 눌러서 읽어주시면 됩니다.
|
23.11.01 |
13,009,246 |
|
공지
|
|
◤더쿠 이용 규칙◢ [스퀘어 정치글은 정치 카테고리에]
|
20.04.29 |
35,395,879 |
|
공지
|
정치 |
[스퀘어게시판 정치 카테고리 추가 및 정치 제외 기능 추가]
|
25.07.22 |
1,080,606 |
|
공지
|
정보 |
더쿠 모바일에서 유튜브 링크 올릴때 주의할 점
785 |
21.08.23 |
8,535,194 |
|
공지
|
정보 |
나는 더쿠에서 움짤을 한 번이라도 올려본 적이 있다 🙋♀️
269 |
20.09.29 |
7,446,345 |
|
공지
|
팁/유용/추천 |
더쿠에 쉽게 동영상을 올려보자 !
3607 |
20.05.17 |
8,656,336 |
|
공지
|
팁/유용/추천 |
슬기로운 더쿠생활 : 더쿠 이용팁
4018 |
20.04.30 |
8,538,217 |
|
공지
|
팁/유용/추천 |
◤스퀘어 공지◢ [9. 스퀘어 저격판 사용 금지(무통보 차단임)]
1236 |
18.08.31 |
14,450,848 |
| 모든 공지 확인하기() |
|
3032695 |
이슈 |
방금자 어떤게 진짜인지 감도 안오는 다영 신곡.........
|
00:29 |
121 |
|
3032694 |
유머 |
결혼하기전에 진돌과의 궁합 사주를 봤던 히디님
1 |
00:27 |
427 |
|
3032693 |
이슈 |
도쿄의 은어라면
|
00:26 |
161 |
|
3032692 |
유머 |
케빈이 처리 못한 나홀로 집에 최고 빌런
8 |
00:25 |
727 |
|
3032691 |
유머 |
공잡으러갔다가 같팀에게 몸통박치기 당한 야구선수
|
00:24 |
258 |
|
3032690 |
이슈 |
아이돌이 두쫀쿠 사달라고 말하는 법
2 |
00:23 |
552 |
|
3032689 |
이슈 |
트럼프, 한국 콕 집어 공개 불만 표출
51 |
00:22 |
1,607 |
|
3032688 |
이슈 |
이미 실사화됐던 <바른연애 길잡이>
9 |
00:22 |
1,013 |
|
3032687 |
기사/뉴스 |
작년부터 일본의 일부 시에서 시행중인 초등학교 7시 등교를 99%가 반대하는 군마,다카사키시 교직원들
6 |
00:20 |
528 |
|
3032686 |
이슈 |
오늘 엠카에서 춤추다가 머리카락의 습격을 받은 여돌ㅠㅋㅋ
1 |
00:19 |
350 |
|
3032685 |
이슈 |
6년전 오늘 발매된, 임영웅 "이제 나만 믿어요"
|
00:18 |
35 |
|
3032684 |
이슈 |
25년 전 오늘 발매된_ "百戰無敗"
3 |
00:18 |
92 |
|
3032683 |
정보 |
TWS(투어스) : Promotion Scheduler 5th Mini Album 'NO TRAGEDY' 🌹 2026.04.27. 6PM (KST)
7 |
00:16 |
247 |
|
3032682 |
유머 |
마운자로 사용에 관한 의사의 조언
2 |
00:15 |
1,349 |
|
3032681 |
이슈 |
1997년 모노노케히메 연출 수준
1 |
00:14 |
490 |
|
3032680 |
이슈 |
🌶 고추맛김
1 |
00:14 |
223 |
|
3032679 |
이슈 |
영파씨 (YOUNG POSSE) 'we don't go to bed tonight' Track Spoiler
|
00:12 |
70 |
|
3032678 |
이슈 |
2000년 드라마속 고등학생들
2 |
00:11 |
455 |
|
3032677 |
이슈 |
반려동물 정책위원회에서 반려동물 동반 출입 음식점 제도에 대해 견주들 의견 대신해주는 설채현 수의사
10 |
00:11 |
856 |
|
3032676 |
이슈 |
mr만 깔고 부르는 쌩라이브 영상으로 결성 13년만에 ”대박“난 일본 여돌
7 |
00:11 |
683 |